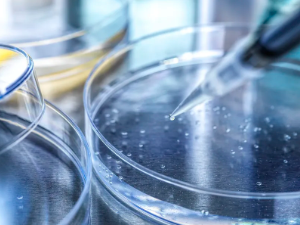
image.png

43醫(yī)院干細胞中心哪家強,治療技術(shù)效果怎樣
2024-11-16 16:01:46 來源: 小編 咨詢醫(yī)生
43醫(yī)院干細胞中心,作為國內(nèi)領(lǐng)先的干細胞研究與應(yīng)用機構(gòu),擁有一支專業(yè)的科研團隊和臨床治療團隊。在干細胞治療技術(shù)方面,該中心具有以下幾個顯著優(yōu)勢:
一、強大的科研實力
43醫(yī)院干細胞中心在干細胞研究領(lǐng)域具有豐富的經(jīng)驗,積極參與國內(nèi)外干細胞研究項目,與多家知名高校和研究機構(gòu)建立了緊密的合作關(guān)系。中心實驗室具備國際一流的研發(fā)設(shè)備,為干細胞研究提供了有力保障。
二、先進的干細胞治療技術(shù)
43醫(yī)院干細胞中心采用先進的干細胞治療技術(shù),包括自體脂肪來源干細胞、骨髓來源干細胞、外周血來源干細胞等。這些技術(shù)具有高度的安全性和有效性,能夠幫助患者改善病情,提高生活質(zhì)量。
以下是43醫(yī)院干細胞中心治療技術(shù)的幾個特點:
1.安全性:采用自體干細胞治療,避免了免疫排斥反應(yīng),降低了感染風(fēng)險。
2.個性化治療:根據(jù)患者病情和體質(zhì),制定個性化的治療方案,確保治療效果。
3.高效性:干細胞治療技術(shù)在短時間內(nèi)即可見效,縮短了治療周期。
4.持續(xù)性:干細胞治療能夠持續(xù)改善患者病情,減少復(fù)發(fā)風(fēng)險。
三、顯著的療效
43醫(yī)院干細胞中心在干細胞治療方面取得了顯著的成果,成功治愈了眾多患者。以下是幾種常見疾病的治療效果:
1.腦梗塞:經(jīng)過干細胞治療,患者肢體運動功能得到明顯改善,言語功能有所恢復(fù)。
2.心肌梗死:干細胞治療能夠促進心肌細胞再生,改善心臟功能。
3.骨折愈合:干細胞治療加速骨折愈合過程,縮短康復(fù)周期。
4.糖尿病足:干細胞治療能夠改善下肢血液循環(huán),減輕疼痛癥狀,避免截肢。
總之,43醫(yī)院干細胞中心在干細胞治療領(lǐng)域具有強大的實力和顯著的優(yōu)勢。通過先進的干細胞治療技術(shù),該中心為眾多患者帶來了福音,成為了國內(nèi)干細胞治療領(lǐng)域的佼佼者。如果您或您的家人朋友患有相關(guān)疾病,不妨咨詢43醫(yī)院干細胞中心,尋求專業(yè)的治療建議。
- 2024-10-28干細胞治療腎癌效果分析
- 2024-10-11干細胞療法適合哪些病癥?效果真的那么神奇?
- 2024-10-26干細胞治療胃癌多久能見效?治療過程是怎樣的?
- 2024-09-30干細胞治療原理是什么,新藥技術(shù)有哪些進展
- 2024-11-27神經(jīng)干細胞療法進展情況如何,有什么應(yīng)用前景
- 2024-10-16進口干細胞治療眼袋效果好嗎?真實案例分享!
- 2024-09-12干細胞十大公司排名,內(nèi)附收費明細表
- 2024-08-03臍帶造血干細胞,臍帶造血干細胞有必要保存嗎
- 2024-10-09臺州干細胞存儲服務(wù)哪家強?存儲流程是怎樣的?
- 2024-10-11干細胞的抗衰老機制是怎樣的?真的能延緩衰老?
- 2024-09-03溫莎之謎干細胞抗衰分析,干細胞護膚品的作用和功效
- 2024-10-11干細胞存儲費用,干細胞存儲的意義是什么
- 2024-09-01造血干細胞存儲價格與條件
- 2024-09-27日本干細胞抗衰老真的有效嗎?有沒有風(fēng)險?
- 2024-09-11干細胞提取過程,干細胞提取方法和設(shè)備
- 2024-10-11 保存骨髓干細胞費用高嗎?具體流程是怎樣的?
- 2024-10-11干細胞抗衰老治療后有哪些注意事項?如何保養(yǎng)?
- 2024-09-13中國干細胞十大公司排名,干細胞什么牌子比較好
